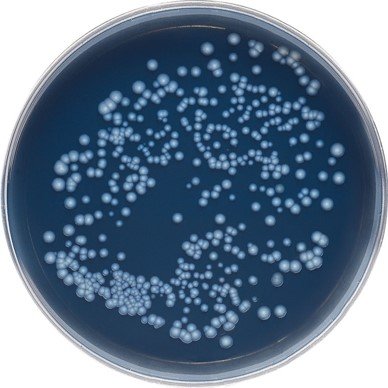

Methods to Measure Waterborne Contaminants Research to Minimize Health Risks
- Microbial Contaminants Methods
- Chemical Contaminant Methods
- Health Effects Methods and Tools
- Related Resources
Protection of our water resources is compromised by shortcomings in our abilities to adequately determine and reduce the full range of human and ecological health risks posed by waterborne contaminants, including chemicals and microbial pathogens.
EPA researchers are developing and evaluating effective tools to measure waterborne contaminants, which are essential for determining the risks these pollutants pose to people and the environment. With these tools, the source and level of contaminants can be evaluated, the risk posed to exposed communities can be characterized, and approaches for improving affected water resources can be developed.
Evaluation and Application of Microbial Contaminants Methods
A key responsibility of the EPA under the Safe Drinking Water Act and the Clean Water Act is to develop methods to detect and quantitate waterborne contaminants, including microbes, that affect water systems. Recent efforts in method development and application have focused on opportunistic pathogens, such as Legionella and Mycobacteria, which are of particular concern for drinking water systems. This work has provided more detail on the frequency and level of contamination of these microbes in commercial and residential water systems. In addition, methods for detecting several enteric viruses were used in a large virus occurrence study, and a comparison of staining kits used for detecting the protozoan pathogen Giardia in source water was conducted.
Advancements are also being made toward the development of rapid, nucleic acid based methods to detect somatic coliphages, which are alternative indicators of fecal pollution and an attractive surrogate for viral pathogens. These methods have the potential to provide evidence of fecal contamination in a matter of hours instead of days.
Recent Research Publications
- Use of a Targeted Method to Link the Resistome to Microbial Hosts in Class B Biosolids (2022) An increasing amount of antibiotics are released into wastewater through different sources, and ultimately find their way into wastewater treatment plants (WWTP). This research provides evidence of the feasibility of using the next generation sequencing (NGS) technology to characterize the wastewater microbial community.
- Estimating virus occurrence using Bayesian modeling in multiple drinking water systems of the U.S. (2018). Water samples were concentrated from 25 drinking water treatment plants (DWTPs) across the US to study the occurrence of enteric viruses in source water and removal after treatment. The five different types of viruses studied were adenovirus, norovirus GI, norovirus GII, enterovirus, and polyomavirus. Quantitative PCR was performed on all samples to determine presence or absence of these viruses in each sample.
- Differences in staining intensities affect reported occurrences and concentrations of Giardia spp. in surface drinking water sources (2017). This study focuses on the differences among staining kits used for Method 1623. Methods and Results Merifluor and EasyStain labeling kits were used to monitor Cryptosporidium oocyst and Giardia cyst densities in New York City's raw surface water sources.
Development and Application of Chemical Contaminant Methods

Developing and using methods and models to measure chemical contaminants is a critical responsibility of the Agency. One recent area of focus has been the development and use of occurrence methods to detect several different classes of contaminants of emerging concern (CECs), including per- and polyfluoroalkyl substances (PFAS) and algal toxins. Collectively this work has helped characterize the level of chemical contamination across the Nation.
Analytical Methods
Per- and Polyfluoroalkyl Substances (PFAS)
- Method 1633: Analysis of Per- and Polyfluoroalkyl Substances (PFAS) in Aqueous, Solid, Biosolids, and Tissue Samples by LC-MS/MS (2022). EPA Draft Method 1633 was published in 2021, and has been made available for laboratories, regulatory authorities, and other interested parties to review the and, where appropriate, utilize it for their own purposes, with the explicit understanding that this is a draft method, subject to revision. The method calibrates and quantifies PFAS analytes using isotopically labeled standards. Where linear and branched isomers are present in the sample and either qualitative or quantitative standards containing branched and linear isomers are commercially available, the PFAS analyte is reported as a single analyte consisting of the sum of the linear and branched isomer concentrations.
- Method 537.1: Determination of Selected Per- and Polyfluorinated Alkyl Substances in Drinking Water by Solid Phase Extraction and Liquid Chromatography/Tandem Mass Spectrometry (2018—editorial updates in 2020*). EPA Method 537 was published in 2009 for the determination of 14 PFAS in drinking water using solid phase extraction (SPE) and liquid chromatography/tandem mass spectrometry (LC/MS/MS). Since the development of Method 537, more PFAS, that have the potential to contaminate drinking water, have been identified or introduced as PFOA/PFOS alternatives in manufacturing. This updated method can now be used to quantitate 18 PFAS in drinking water, including HFPO-DA (one component of the GenX processing aid technology) and three additional PFAS.
*NOTE: Method 537.1 was updated in 2020 to version 2.0. The only updates were editorial and did not include any technical revisions. - Method 537: Determination of Selected Perfluorinated Alkyl Acids in Drinking Water by SPE and LC/MS/MS (2009). EPA Method for the determination of 14 PFAS in drinking water using SPE and lLC/MS/MS. This method was updated in 2018 to Method 537.1 (above).
Cyanotoxins
- EPA Method 546: Determination of Total Microcystins and Nodularins in Drinking Water and Ambient Water by Adda Enzyme-Linked Immunosorbent Assay (2016). This method is used for the determination of total microcystins and nodularins in finished drinking water and in ambient water using ELISA. It measures the total concentration based on detection of a characteristic feature common to microcystin and nodularin congeners (structural variants).
- EPA Method 545: Determination of Cylindrospermopsin and Anatoxin-a in Drinking Water by Liquid Chromatography Electrospray Ionization Tandem Mass Spectrometry (2015). This method is used for the determination of the algal toxins, cylindrospermopsin and anatoxin-a, in finished drinking water. Method 545 requires the use of MS/MS in Multiple Reaction Monitoring (MRM) mode to enhance selectivity. It is intended for use by analysts skilled in the operation of LC/ESI-MS/MS instrumentation and the interpretation of the associated data.
- EPA Method 544: Determination of Microcystins and Nodularin in Drinking Water by Solid Phase Extraction and Liquid Chromatography/Tandem Mass Spectrometry (2015). This method is used to determine six microcystins (including MC-LR) and nodularin in drinking water using SPE-LC/MS/MS. The advantage of this SPE-LC/MS/MS is its sensitivity and ability to speciate the microcystins. This method development task establishes sample preservation techniques, sample concentration and analytical procedures, aqueous and extract holding time criteria, and quality control procedures.
Technical Briefs
- PFAS Reviewing Analytical Methods Data for Environmental Samples-Technical Brief (pdf)
- PFAS methods and guidance for sampling and analyzing water and other environmental media-Technical Brief (pdf)
Recent Research Publications
- PFAS in source and treated drinking waters of the U.S. (2018). This study measured 17 PFAS in source and treated water from 25 drinking water treatment plants as part of a broader study of CECs in drinking water across the Nation.
- Modeled de facto reuse and CECs in drinking water source waters (2018). Results from grab samples and a de facto reuse in our Nation's consumable supply geospatial watershed model were used to quantify CEC concentrations at DWTP intakes to qualitatively compare exposure risks obtained by the two approaches.
- An introduction to joint research by the USEPA and USGS on CECs in source and treated drinking waters of the U.S. (2017). This paper is an introduction to a series of papers that provide important baseline information on the concentrations of CECs from principal source-water types (e.g. surface water, groundwater). Sampling sites were located across a range of hydrologic, climatic, and demographic conditions and were treated using a variety of drinking-water treatment practices commonly used across the Nation.
- Nationwide reconnaissance of CECs in source and treated drinking waters of the U.S.: Pharmaceuticals (2017). A joint, two-phase U.S. Geological Survey (USGS)/EPA study that examined source and treated waters from 25 drinking-water treatment plants from across the United States to assess the prevalence of pharmaceuticals in such source waters, and to identify which pharmaceuticals persist through drinking-water treatment.
- Nationwide reconnaissance of CECs in source and treated drinking waters of the U.S. (2017). Source and treated drinking water samples from 29 drinking water treatment plants (DWTPs) were analyzed as part of a two-phase study to determine whether chemical and microbial constituents, many of which are considered contaminants of emerging concern, were detectable in the waters.
- The importance of quality control in validating CECs in source and treated drinking water samples (2017). A national-scale survey of 247 CECs, including organic and inorganic chemical compounds, and microbial contaminants, was conducted in source and treated drinking water samples from 25 DWTPs across the Nation. Multiple methods were used to determine these CECs, including six analytical methods to measure 174 pharmaceuticals, personal care products, and pesticides.
- Aquatic concentrations of chemical analytes compared to ecotoxicity estimates (2017). Collaborative USGS/EPA study that conducted screening level estimates of potential aquatic toxicity posed by 227 chemical analytes that were measured in 25 ambient water samples.
- Expanded target-chemical analysis reveals extensive mixed-organic-contaminant exposure in U.S. Streams (2017). Collaborative USGS/EPA study to survey surface waters from 38 streams nationwide for chemical contaminants and biological activity. The study examined the occurrence and concentrations of over 700 target analytes in surface waters from a broad range of streams representing a gradient of urban, agriculture, and undeveloped land use, a broad range of geologies and ecoregions, and multiple EPA Regions.
Health Effects Methods and Tools

Tools that enable EPA to measure the impact of contaminants on human health and the environment are essential for determining the risk posed by pollutants. Recent efforts have focused on the use of novel bioassays, such as those based on Adverse Outcome Pathways (AOPs) or metabolomic techniques, to assess the risk posed by various chemical pollutants. In addition, large scale studies aimed at determining the public health or environmental significance of chemical contaminants were done. This work has significantly improved our understanding of the health risks posed by chemical contaminants.
Technical Brief
Research on Bioassays for Evaluating Water Quality (2018)
Table of Existing Bioassays
Assay | Description | References |
---|---|---|
T47D-KBluc | Human breast cancer cell line that naturally expresses estrogen receptors and has been engineered to stably express an estrogen responsive reporter gene (luciferase). Estrogenic compounds in a sample will bind estrogen receptors, dimerize and then bind to DNA and activate expression of the reporter gene. The reporter gene catalyzes a reaction that is measured in light units. The more potent the estrogen, the more light produced. |
Wilson, V.S., Bobseine, K., Gray, L.E. (2004) Development and characterization of a cell line that stably expresses an estrogen-responsive luciferase reporter for the detection of estrogen agonist and antagonists. Toxicol Sci 81, 69-77. |
MDA-kb2 | Similar to above, a human breast cancer cell line that naturally expresses androgen and glucocorticoid receptors and has been engineered to stably express a luciferase reporter gene. Compounds that bind either androgen or glucocorticoid receptors can activate the reporter gene. The use of an androgen receptor specific inhibitor can differentiate between AR and GR activity. |
Wilson, V.S., Bobseine, K., Lambright, C.R., Gray, L.E. (2002) A novel cell line, MDA-kb2, that stably expresses an androgen- and glucocorticoid-responsive reporter for the detection of hormone receptor agonists and antagonists. Toxicol Sci 66 69-81. |
CV-1 transient GR assay | Monkey kidney cells are transfected (infected) with two different Adenoviruses. One has the GR or AR gene and the other a reporter gene. Both genes are expressed. The chemical (water) turns binds the GR or AR gene product, which in turn, activates the reporter, which can produce light which can be measured. The more light, the more chemical in the water. |
Shih, W., Mears, T., Bradley, D.J., Parandoosh, Z., and Weinberger, C. (1991). An adenoviral vector system for functional identification of nuclear receptor ligands. Mol Endocrinol. 5, 300-309. Hartig, P. C., M. Cardon, C. Blystone, L. E. Gray Jr., and V. Wilson. 2008. High Throughput Adjustable 96 Well Plate Assay for Androgen Receptor Binding: A Practical Approach for EDC Screening using the Chimpanzee AR. Tox Lett. 181:126-131. |
Steroidogenesis Pimephales promelas | Water samples are used to prepare tissue culture medium. Ovary tissue from control fathead minnows are incubated in the medium for 12 hours and concentrations of 17b-estradiol (E2) and testosterone (T) excreted into the medium are measured by radio-immunoassay. The assay provides an indication of whether contaminants in the water sample are capable of inhibiting key enzymes or reactions involved in steroid hormone biosynthesis. |
Villeneuve et al. 2007. Comparison of fathead minnow ovary explant and H295R cell-based steroidogenesis assays for identifying endocrine-active chemicals. Ecotoxicol. Environ. Safety. 68: 20-32. |
Gene expression Pimephales promelas | The gene expression work complements the steroidogenesis assay above. Specifically, if significant effects on either E2 or T production are observed, real-time PCR will be used to determine if in vitro exposure to the water samples resulted in altered expression of genes coding for key, rate limiting, enzymes involved in steroid biosynthesis. |
Villeneuve et al. 2007. Transcription of key genes regulating gonadal steroidogenesis in control and ketoconazole- or vinclozolin-exposed fathead minnows. Toxicol. Sci. 98: 395-407 |
Nuclear receptor and transcription factor activation | Extracts of selected water samples from the WW2DW project will be analyzed using the Attagene battery of Toxcast assays. Attagene employs a HepG2 cell line transfected with libraries of cis- and trans-regulated transcription factor reporter constructs to simultaneously evaluate approximately 80 different transcription factor activities. |
Martin et al. 2010. Impact of environmental chemicals on key transcription regulators and correlation to toxicity endpoints within EPA’s ToxCast Program. Chem. Res. Toxicol. 23: 578-590. |
Metabolite profiling Danio rerio | Endogenous metabolites in zebrafish (Danio rerio) liver cells will be extracted and analyzed by nuclear magnetic resonance spectroscopy and mass spectrometry to determine biochemical pathways impacted by exposure to collected surface waters. Measured impacts on biochemical pathways will be used to determine the primary toxicity of the water samples. | |
RNA-seq | This method employs next generation sequencing to provide a global picture of the levels of expression within exposed organisms (larval FHM). We are addressing additional questions regarding the consistency of the expression profile over time and sites (upstream and effluent) as well as grab sample vs. deployment. | |
Mutagenicity Ames assay with and without metabolic activation | The Ames mutagenicity assay allows the water samples collected and extracted in this study to be compared to the existing literature on the mutagenicity of water. For complex mixtures of water contaminants, the Ames assay provides the richest database to date. |
General reference: Warren SH, Claxton LD, Diliberto J, Hughes TJ, Swank A, Kusnierz DH, Marshall V, DeMarini DM, Survey of the mutagenicity of surface water, sediments, and drinking water from the Penobscot Indian Nation, Chemosphere, 120: 690-696, 2015. |
Microtox assay | The Microtox assay is a rapid screening assay for water samples that uses bioluminescent bacteria to detect toxicants in water. The assay has undergone verification by the Environmental Technology Program. |
The Environmental Technology Verification Program: ETV Joint Verification Statement, MicroTox for Detecting Toxicity in Drinking Water (“ETV Joint Verification Statement” EPA Environmental Technology Verification Program. EPA. Retrieved 10-7-15) |
Algae Microplate Assay | Algae (Raphidocelis subcapitata) are exposed to individual chemicals, chemical mixtures, or environmental sample extracts for 24 hours using 96-well microplates. Exposure effects e.g., biomass, photosynthesis, photosynthetic pigment concentrations, and algal cell viability are quantified using a microplate reader. |
Disclaimer: This table has been provided for informational purposes only. Any mention of or reference to commercial products, processes, or services by trade name, trademark, manufacturer, or otherwise does not imply an endorsement by EPA. EPA does not endorse any commercial products, services, or enterprises.
Recent Research Publications
- Current Breast Milk PFAS Levels in the United States and Canada: After All This Time, Why Don’t We Know More? (2022) This work documented published PFAS breast milk concentrations in the United States and Canada; estimated breast milk PFAS levels from maternal serum concentrations in national surveys and communities impacted by PFAS; and compared measured/estimated milk PFAS concentrations to screening values.
- Effects-Based Monitoring of Bioactive Chemicals Discharged to the Colorado River before and after a Municipal Wastewater Treatment Plant (WWTP) Replacement (2021). This study highlights the utility of bioeffects-based monitoring in conjunction with analytical chemical measurements of surface waters on the Colorado River associated with a historically bioactive wastewater treatment plant effluent.
- Legionella: A Promising Supplementary Indicator of Microbial Drinking Water Quality in Municipal Engineered Water Systems (2021). Opportunistic pathogens (OPs) are natural inhabitants and the predominant disease causative biotic agents in municipal engineered water systems (EWS). This research reviews Legionella as an effective indicator of microbial drinking water quality in water systems, as it may indicate the presence and concentrations of other OPs in an EWS through comparing OP behavior (i.e., occurrence, growth and regrowth, spatiotemporal variations in concentrations, resistance to disinfectant residuals, and responses to physicochemical water quality parameters).
- De Facto Water Reuse: Bioassay suite approach delivers depth and breadth in endocrine active compound detection (2020) Bioassays were used to determine presence of contaminants in environmental samples and to determine efficiency of drinking water treatment on removal of environmental contaminants in impacted source water.
- Adverse outcome pathways to support the assessment of chemical mixtures (2018). Covers some of the potential applications for AOPs when performing risk assessment of chemical mixtures. The structure of the AOP provides much more precision when considering mechanistic data in a mixtures assessment.
- Predicting mixture toxicity with models of additivity (2018). Provides background on several of the common additivity models, illustrates their application with examples, and discusses their advantages and limitations.
- Assessing the impact of wastewater treatment plant effluent on downstream drinking water-source quality using a zebrafish (Danio rerio) liver cell-based metabolomics approach (2018). Cell-based metabolomics was used in a proof-of-concept fashion to investigate the biological effects of contaminants as they traveled from a wastewater treatment plant discharge to a drinking water treatment plant (DWTP) intake in a surface water usage cycle.
- Human health screening and public health significance of contaminants of emerging concern detected in public water supplies (2017). Source water and treated drinking water from twenty-five drinking water treatment plants (DWTPs) across the United States were sampled and analyzed for 247 contaminants using 15 chemical and microbiological methods. Most of these contaminants are not regulated currently either in drinking water or in discharges to ambient water by EPA or other U.S. regulatory agencies.
- Occurrence and in vitro bioactivity of estrogen, androgen, and glucocorticoid compounds in a nationwide screen of United States stream waters (2017). Collaborative U.S. Geological Survey/EPA study to better define what chemicals occur in streams of the U.S. and their concentrations, what land-use practices influence the composition of chemical mixtures, and whether exposure of fish and other aquatic organisms to these mixtures may result in adverse health effects.
- Tools to minimize interlaboratory variability in vitellogenin gene expression monitoring programs (2017). Interlaboratory study on QPCR methods for detection of estrogen exposures using fathead minnows and gene expression. It demonstrates that the gene expression method for vitellogenin gene is very robust and can be reliable when the same samples are measured by various laboratories using different equipment and kits.
- Comparison of in vitro estrogenic activity and estrogen concentrations in source and treated waters from 25 U.S. drinking water treatment plants (2016). Source and treated drinking water samples were assayed for estrogenic activity using T47D-KBluc cells and analyzed by LC-MS/MS for natural and synthetic estrogens (including estrone, 17B-estradiol, estriol, and ethinyl estradiol).
- Effect-based screening methods for water quality characterization will augment conventional analyte-by-analyte chemical methods in research and regulatory monitoring (2014). Describes the potential of bioassays when applied to criteria development, water quality monitoring, and impact assessment.